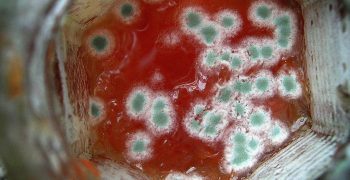

RIA Restoration Blog
Greater Greater Washington (12/06/19) Meena Morar
Restoration & Remediation (11/18/19)
Military.com (12/03/2019) Rose L. Thayer
By definition, complacency is a lack of energy. In the military, we say complacency kills! This is as true in business as it is in battle.
RIA Australasian Council names Oliver Threlfall the 2019 Lifetime Achievement Award winner.
This is an RIA member-only benefit. If you would like to access this resource, please join today at restorationindustry.org.
Rachel Stewart is the executive vice president of Titan Restoration of Arizona. She has been in the industry close to 11 years.
Regency DRT/DKI received the 2019 RIA Phoenix Award for Innovation in Restoration.
The Hill (11/11/19) Justine Coleman
Business Insurance (10/30/19) Angela Childers